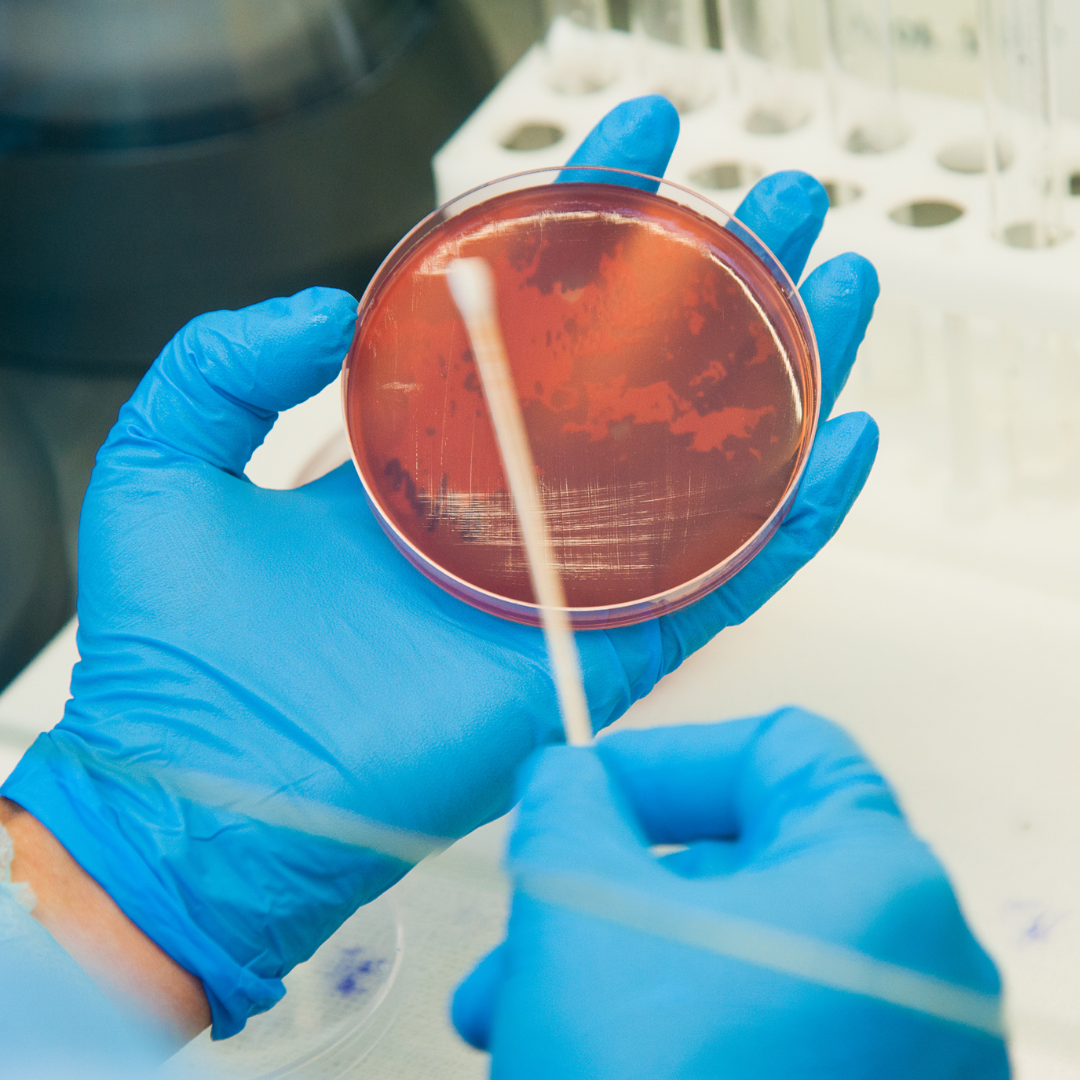
2 2

Future Med Prep Programme คืออะไร?
Explore the Program
Future Med Prep Programme: โปรแกรมเตรียมสอบแพทยศาสตร์ครบวงจร One Stop Service สำหรับนักเรียน ม.4 ขึ้นไป หรือเทียบเท่า เรียนแบบ Hybrid ทั้งออนไลน์และออฟไลน์ ครอบคลุมทุกวิชาที่ใช้สอบแพทย์ พร้อมการทำพอร์ตโฟลิโอ พัฒนา Soft Skills ผ่าน Workshop และ Bootcamp รวมทั้งพาน้องๆสร้างองค์ความรู้และตัวตนให้โดดเด่นกว่าใคร ผ่านงานวิจัย Research Project ด้านนวัตกรรมการแพทย์ และมีผู้เชี่ยวชาญพร้อมพาน้องแข่งขันชิงรางวัลในระดับประเทศ โดยใช้ระยะเวลาการเรียนทั้งหลักสูตร 1 ปี 6 เดือน ผู้เรียนทุกคนจะได้รับบริการสุดพิเศษ Med Elite Support ที่ทำให้การสมัครสอบและเตรียมเอกสารเป็นเรื่องง่ายมีทีมพร้อมซับพอร์ต และแจ้งเตือนทุกการสอบในทุกคณะแพทย์ที่น้องตั้งเป้าหมาย
เหมาะสำหรับ: นักเรียน ม.4-5 ที่สนใจศึกษาต่อคณะแพทยศาสตร์ และต้องการการวางแผนการเรียนแบบครบวงจร
ระยะเวลา 1 ปี 6 เดือน
ค่าเรียน 259,900 ตลอดหลักสูตร
จุดเด่นของหลักสูตร FutureMed Prep
สู่เส้นทางการเรียนต่อแพทยศาสตร์อย่างมั่นใจด้วยโปรแกรมครบวงจร
ครบจบในที่เดียว
ให้บริการแบบ One-Stop Services ครอบคลุมทุกความต้องการ ตั้งแต่การวางแผนการเรียนเฉพาะบุคคลไปจนถึงการสมัครสอบ ติดตามผลและประเมินผู้เรียนจนถึงวันยื่นคะแนน
สร้างความแตกต่าง
การเรียนรู้ประสบการณ์จริงผ่านกิจกรรม Bootcamp จากผู้เชี่ยวชาญและการทำโปรเจกต์วิจัยนวัตกรรมด้านการแพทย์ หรือโครงงานแข่งขันเพื่อสร้างความโดดเด่นให้ผู้เรียนดูโดดเด่นกว่าทุกคน
เรียนรู้แบบ Hybrid
ผสมผสานการเรียนออนไลน์และออฟไลน์ เพื่อให้การเรียนมีความยืดหยุ่นครอบคลุมทุกเนื้อหาต่อการสอบเข้าแพทย์ในทุกวิชา ทั้งการติวเข้มวิชาเฉพาะ การฝึกทักษะBootcamp และพัฒนางานวิจัยตามDNAที่แต่ละมหาวิทยาลัยต้องการ
รายละเอียดโครงสร้างโปรแกรม
ทั้งหมดนี้คือหัวข้อที่ผู้เรียนจะได้รับจากโปรแกรม เพื่อมุ่งสู่เส้นทางแพทยศาสตร์อย่างมั่นใจด้วยโปรแกรมแบบครบวงจร
-
Planning วางแผนครบทั้งระบบ
การวางแผนการเรียนกับอาจารย์ผู้เชี่ยวชาญส่วนบุคคลเป็นแนวทางที่จะช่วยให้นักเรียนสามารถพัฒนาความรู้และทักษะได้อย่างเต็มประสิทธิภาพ เพราะแผนการเรียนนี้ถูกออกแบบเฉพาะเจาะจงให้เหมาะกับความต้องการและเป้าหมายของแต่ละคน
-
English Proficiency เตรียมคะแนนภาษาให้พร้อม
การเตรียมตัวเพื่อสอบวัดความสามารถทางภาษาอังกฤษ เช่น IELTS หรือ TOEFL ต้องมีการวางแผนอย่างเป็นระบบและมีเป้าหมายที่ชัดเจนเพื่อเพียงพอต่อการยื่นคณะในฝันของผู้เรียน
-
Standardize Test ครบทุกวิชาพร้อมยื่นทุกที่
การเตรียมตัวสอบมาตรฐานสำหรับการสอบ TBAT, CU-AAT หรือ MCAT จำเป็นต้องมีแผนการเรียนและการฝึกฝนที่ชัดเจนเพื่อทำคะแนนให้ถึงเป้าหมาย ในที่นี้มีคำแนะนำในการเตรียมตัวสำหรับแต่ละการ ในกรณีที่ผู้เรียนยื่นเข้าคณะอื่นสามารถวิชาอื่นแทนได้ เช่น UCAT/AKAT
-
Statement of Purpose สร้างความโดดเด่นจากตัวตน
Statement of Purpose (SOP) วิชาผู้สมัครศึกษาต่อใช้เพื่อแสดงเจตจำนงในการเรียนในระดับที่สูงขึ้น โดยรายวิชา SOP มักมุ่งเน้นให้นักเรียนสามารถเขียน SOP ที่มีคุณภาพสูงและสามารถนำเสนอจุดเด่นของตนเองได้อย่างมีประสิทธิภาพ
-
MMIs (Multiple Mini Interviews) สัมภาษณ์ได้อย่างมั่นใจ
MMIs (Multiple Mini Interviews) เป็นรูปแบบการสัมภาษณ์ที่ใช้ในกระบวนการคัดเลือกผู้สมัครเข้าคณะแพทยศาสตร์และหลักสูตรที่ต้องการประเมินความสามารถในด้านที่เกี่ยวข้องกับการทำงานในสายวิชาชีพเฉพาะ เช่น แพทย์ เภสัชกร หรือสาขาด้านสุขภาพ โดยการสัมภาษณ์ MMIs จะประกอบด้วยการสัมภาษณ์สั้นหลายสถานี (stations) ซึ่งช่วยให้ผู้คัดเลือกสามารถประเมินทักษะของผู้สมัครในหลากหลายด้านได้อย่างครอบคลุมและเป็นธรรม
-
Workshop (Intro to Medicine: Skills & Mindset) ครบทุกทักษะที่คณะแพทย์ต้องการ
เวิร์กชอปที่ออกแบบมาเพื่อเตรียมความพร้อมพื้นฐานที่สำคัญสำหรับการเข้าสู่โลกการแพทย์ โดยเน้นพัฒนาทักษะและแนวคิดที่จำเป็นสำหรับนักเรียนที่มีความฝันอยากเป็นแพทย์หรือทำงานในสายการแพทย์ ประกอบไปด้วยหัวข้อสำคัญดังนี้:ทักษะพื้นฐานทางการแพทย์, การพัฒนาแนวคิดการเป็นแพทย์มืออาชีพ, การพัฒนาทักษะการแก้ปัญหา ผ่านกิจกรรม Workshop ที่ทางหลักสูตรจัดขึ้น
-
Medical Bootcamp สู่ประสบการณ์ทางการแพทย์
ผู้เรียนจะได้ติดตามแพทย์และผู้เชี่ยวชาญในด้านการแพทย์ในสถานพยาบาลและสถานที่หลากหลายรูปแบบ และการฝึกปฏิบัติในเวิร์กช็อป เพื่อเสริมทักษะพื้นฐานที่จำเป็น เช่น การวัดสัญญาณชีพ การสื่อสารกับผู้ป่วย และการฝึกปฏิบัติการทางการแพทย์ขั้นพื้นฐาน เพื่อสร้างทักษะที่โดดเด่น
-
Medical and Innovation Research Project สร้างDNAนักวิจัยอย่างมีคุณภาพ
โปรเจกต์งานวิจัยนี้ให้โอกาสนักเรียนที่สนใจการแพทย์และนวัตกรรมได้ทำงานวิจัยและพัฒนาไอเดียใหม่ๆ ที่สามารถแก้ปัญหาหรือพัฒนางานด้านการแพทย์ และสร้างตัวตนให้โดดเด่นผ่านงานวิจัยนวัตกรรมวิทยาศาสตร์สุขภาพ และโครงงานแข่งขันเกี่ยวกับนวัตกรรมวิทยาศาสตร์สุขภาพ พร้อมผู้เชี่ยวชาญแนะนำการแข่งขันระดับประเทศ
-
Portfolio Pro for Future Medics สร้างพอร์ตให้โดดเด่นกว่าใคร
คอร์สนี้ออกแบบมาเพื่อช่วยนักเรียนที่มีความฝันอยากเรียนแพทย์ สร้างพอร์ตโฟลิโอที่โดดเด่น สะท้อนตัวตนและศักยภาพได้อย่างเต็มที่ ผ่านกระบวนการที่เป็นระบบและการให้คำปรึกษาจากผู้เชี่ยวชาญที่มีประสบการณ์ในสายงานแพทย์
-
Med Skills Boost เสริมจุดแข็งอุดจุดอ่อนให้วิชาการแข็งแกร่ง
Med Skills Boost คือโปรแกรมติดตามพัฒนาการของผู้เรียนโดยทีมวิชาการ และแพทย์ประจำโครงการเพื่อแนะนำติดตามเรียนรู้ของผู้เรียนแบบตัวต่อตัวให้พร้อมปรับปรุงทักษะในด้านที่บกพร่องเพื่อเตรียมตัวให้พร้อมที่สุดสำหรับการเรียนแพทย์
Med Elite Support Program
เสริมจุดแข็งปิดจุดอ่อน
คือโปรแกรมการสนับสนุนที่ออกแบบมาเพื่อช่วยให้นักเรียนที่มีเป้าหมายจะเป็นแพทย์ ได้รับคำแนะนำและการพัฒนาอย่างครบวงจร ตั้งแต่การเตรียมตัวสำหรับการสมัครสอบแพทย์จนถึงการเสริมสร้างทักษะต่างๆ ที่จำเป็นในการเข้าสู่เส้นทางแพทย์ นี่คือหนึ่งในบริการที่คุณจะได้รับจากหลักสูตร
หมดห่วงเรื่องเอกสารและการสมัครสอบ
การสนับสนุนการสมัครสอบ: ทีมซับพอร์ตของเราจะช่วยแจ้งข่าวสารเกี่ยวกับการสมัครสอบต่างๆ และให้คำปรึกษาในการเตรียมตัวสมัครในคณะที่น้องติดตาม พร้อมอัพเดทข้อมูลทุกเดือน
ได้คำปรึกษาจากทีมแพทย์ตลอดหลักสูตร
การให้คำปรึกษาจากแพทย์: พบกับทีม Program Director ที่เป็นหมอจริงๆ ทุก 6 เดือน เพื่อให้คำแนะนำในการเตรียมตัวเรียนแพทย์ และแบ่งปันประสบการณ์จากผู้ที่มีความเชี่ยวชาญในสายงาน
ได้รับคำแนะนำด้านวิชาการจากผู้สอน
คำปรึกษาด้านวิชาการ: ทุก 3 เดือนผู้เรียนจะได้พบกับอาจารย์ผู้สอนวิชาการทางวิทยาศาสตร์ เพื่อเสริมสร้างพื้นฐานที่แข็งแกร่งในการเรียนวิชาสายแพทย์
Integrated Training & Research Program
สร้างทักษะทางการแพทย์ให้โดดเด่นด้วย

Workshop (Intro to Medicine: Skills & Mindset)
เวิร์คช้อปนี้เป็นการแนะนำทักษะและกรอบความคิดสำหรับการเป็นแพทย์ ผู้เรียนจะได้ฝึกทักษะทางการแพทย์เบื้องต้น เช่น การตรวจร่างกายและการสื่อสารกับผู้ป่วย พร้อมทั้งเรียนรู้การปรับตัวและจริยธรรมในสภาพแวดล้อมทางการแพทย์ที่มีความกดดันสูง
Medical Bootcamp
บูทแคมป์นี้ให้ผู้เรียนได้สัมผัสประสบการณ์จริงในสภาพแวดล้อมทางการแพทย์ผ่านการสังเกตการทำงานของแพทย์และเจ้าหน้าที่ทางการแพทย์ ผู้เรียนจะได้เรียนรู้วิธีการตรวจและวินิจฉัยเบื้องต้น การสื่อสารกับผู้ป่วย และการจัดการกรณีฉุกเฉิน โดยกิจกรรมนี้ออกแบบมาเพื่อเสริมสร้างความเข้าใจในวิชาชีพและสร้างแรงบันดาลใจให้กับผู้ที่ต้องการประกอบอาชีพด้านการแพทย์

Medical and Innovation Research Project
โปรเจควิจัยนี้มุ่งเน้นให้ผู้เรียนได้ศึกษาและทำวิจัยในหัวข้อทางการแพทย์และนวัตกรรมที่เกี่ยวข้อง ภายใต้การแนะนำจากผู้เชี่ยวชาญ ผู้เรียนจะได้เรียนรู้วิธีการออกแบบและดำเนินการวิจัย รวมถึงการวิเคราะห์ข้อมูลและนำเสนอผลการวิจัย โดยโปรเจคนี้จะช่วยพัฒนาทักษะการคิดวิเคราะห์ ความเข้าใจเชิงลึกในหัวข้อวิจัย และส่งเสริมการสร้างสรรค์นวัตกรรมที่สามารถนำไปประยุกต์ใช้จริงในวงการแพทย์ หรือสำหรับการแข่งขัน
โปรแกรมนี้เหมาะกับใคร?
-
นักเรียนชั้น ม.4-5 หรือเทียบเท่า
ผู้สมัครควรอยู่ในช่วงอายุประมาณ 15-18 ปี หรือ Grade 10 ในหลักสูตรอเมริกา และ Year 11 ในหลักสูตรอังกฤษ ขึ้นไป ทั้งนี้ช่วงเวลาเตรียมตัวที่ดีที่สุดคือ ม.4 ไม่เกิน ม.5 หรือเทียบเท่า
-
มีความสนใจในคณะแพทย์ศาสตร์
ผู้สมัครมีความสนใจในการศึกษาต่อคณะแพทยศาสตร์มหาวิทยาลัยในไทย โดยมีความมุ่งมั่น และพร้อมเรียนรู้ไปตามแผนการเรียนของโปรแกรม
-
เกรดเฉลี่ยสะสมสูงกว่า 3.0
โดยปกติแล้วคณะแพทยศาสตร์ส่วนใหญ่จะใช้เกรดเฉลี่ย 3.0-3.5 หรือเทียบเท่าโดยจะต้องมีคะแนนในรายวิชา เคมี ชีวะ ฟิสิกส์(หรือคณิตศาสตร์) แต่ทั้งนี้อาจจะมีบางมหาวิทยาลัยที่ไม่กำหนดเกรดเฉลี่ยขั้นต่ำซึ่งที่ปรึกษาการเรียนต่อจะให้คำปรึกษากับท่านแล้วแต่กรณี
-
ต้องการวางแผนทั้งระบบ
นักเรียนต้องการวางแผนการศึกษาต่อ เตรียมคะแนนสอบวิชาเฉพาะให้ครบถ้วน รวมถึงการสร้างทักษะ Soft Skills ให้พร้อมสำหรับยื่นคะแนนในรอบ Portfolio และฝึกฝนสร้างตัวตนให้โดดเด่นตั้งแต่เริ่มต้น
ค่าใช้จ่ายตลอดหลักสูตร
259,900 Baht
สิ่งที่นักเรียนจะได้รับ
-
คอร์สเรียนเนื้อหาวิชาการแบบเต็มรูปแบบ
-
โปรแกรมดูแลแบบใกล้ชิด Med Elite Support Programme
-
ได้รับใบประกาศนียบัตร และเข้าร่วมWorkshopทางการแพทย์
-
ได้รับคำปรึกษาจากทีมวิชาการ, และทีมอาจารย์แพทย์อย่างใกล้ชิดตลอดหลักสูตร
-
เข้าร่วมโปรแกรมฝึกทักษะการแพทย์จากโรงพยาบาลโดยตรง
-
หมดห่วงเรื่อง Admission Requirement เปลี่ยนแปลงเพราะหลักสูตรจะดูแลจนครบโปรแกรม